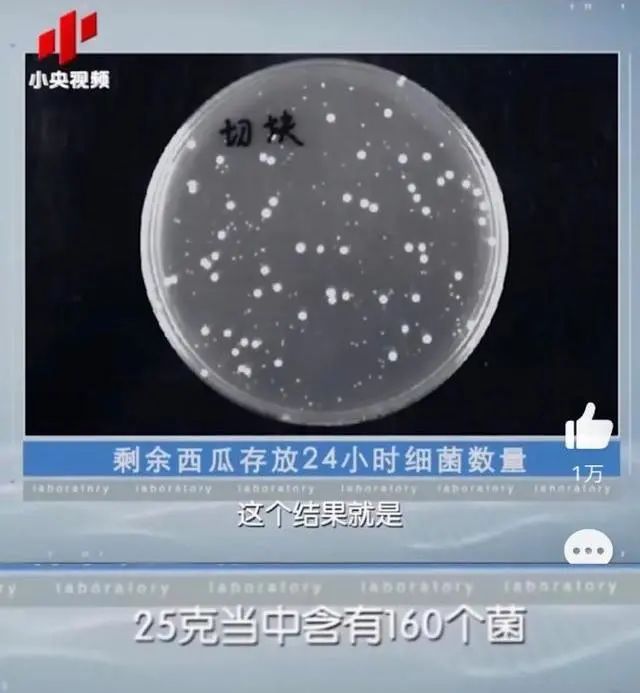

原创 郝小娟 有来医生 收录于话题#健康热点36个
试问,酷暑季节,谁的仙气不是靠一口冰西瓜吊着?
然而,一项实验对冰箱中冷藏24小时的西瓜进行细菌检测,发现25g西瓜中就含有160个菌。
冰镇西瓜,储存不当,可能就是个细菌培植皿,对人体有很大危害!
此前,广东疾控部门就曾报道过相关案例:50岁大妈吃隔夜冰西瓜险丧命!


1.切瓜时,使用不干净的菜刀和砧板(尤其是混用切完生肉后的刀具),会让西瓜表面细菌剧增。
实验数据表明:将切完肉的刀板简单清洗后继续切西瓜,每25g西瓜中,就含有8400个细菌。

2.西瓜切开后,若未及时放入冰箱,易被细菌感染。
3.冷藏时,没有将西瓜用保鲜膜裹紧或使用不干净的保鲜膜,也可能滋生细菌。
4. 将冰箱当成“贮藏柜”,生熟不分、存放杂物、积霜严重,容易导致冰箱内生熟食品交叉污染,甚至为食物中毒埋下隐患。


1.区分生熟
生食中往往含有寄生虫和细菌,和熟食放在一起,会污染熟食。
2.食物存放留间隙
冰箱食物存放应留有一定间隙,不仅可以延长冰箱寿命,还能避免食物间细菌交叉传染。

3.食物分装
肉类食物如需冷冻,可事先按需按量切块分装好,以免反复解冻,导致细菌滋生。
4.先处理后存放
蔬菜水果可以擦干水分后放入冰箱,熟食可以用保鲜盒装好后放入冰箱。
5.瓶装饮料不冷冻
玻璃瓶装饮料适宜冷藏,冷冻可能导致瓶身炸裂。
6.过烫食物先不放
过烫食物可能会加大冰箱运转负荷,缩短冰箱寿命。

▲存放时间一览表

冰箱不是“保险柜”,它只能适当延缓食物变质时间,如果长时间不清洁,它会成为“细菌聚集地”。定期清理,对冰箱以及食物本身,都有益无害。
��避免食物间串味,影响新食物口味
��避免变质食物污染冰箱
��减少冰箱耗电

夏季吃瓜利消暑,但也要避开错误做法哦~
否则,小心「续命西瓜」变成「要命西瓜」!
| 封面图源:摄图网 |
| 正文图源:小央视频&网络 |
